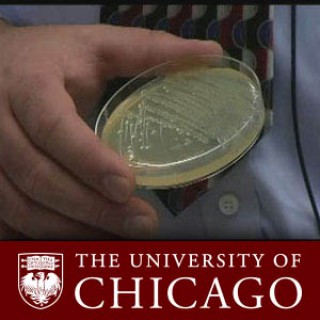

Connecting to Apple Music.

If you experience any technical difficulties with this video or would like to make an accessibility-related request, please send a message to digicomm@uchicago.edu.

If you experience any technical difficulties with this video or would like to make an accessibility-related request, please send a message to digicomm@uchicago.edu. New research led by University of Chicago Professor Olaf Schneewind on the mechanisms that bacteria use to cause human disease may help produce new therapeutics. Copyright 2005 The University of Chicago.
If you experience any technical difficulties with this video or would like to make an accessibility-related request, please send a message to digicomm@uchicago.edu. Pandemic is a scary word. It summons images of the 1918 global influenza pandemic, which claimed perhaps 60 million lives and continues to shape our responses to influenza today.But in light of the new swine flu reported in Mexico and in parts of this country, we should remember that a pandemic can take many different forms, some more dangerous than others. By the World Health Organization's reckoning, the current situation has not yet progressed enough to be called a full-fledged pandemic. Even if it becomes one, it appears, at least at this early stage, to share many features with the seasonal flu we see every year.The familiar seasonal flu is serious enough to kill up to 20,000 people in most flu seasons. But our lengthy experience with the common virus should render the current outbreak less mysterious and alarming than that imposing word "pandemic" might suggest.